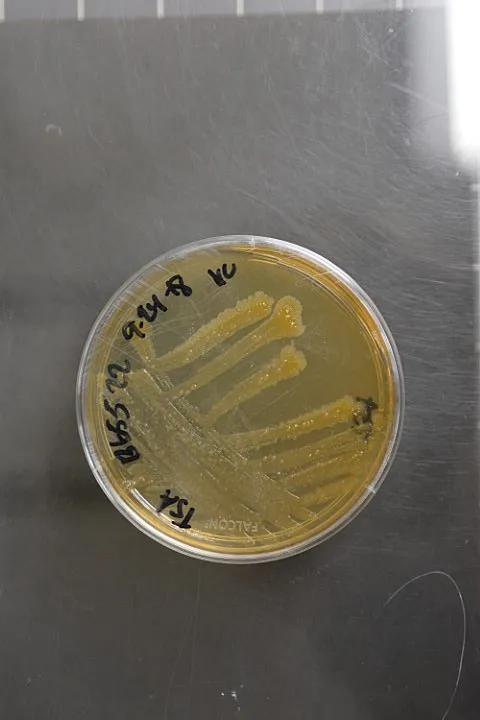
Pantoea piersonii, formerly Kalamiella piersonii NRRL B-65522 (Type Strain) Accession numbers in other collections: IIIF1SW-P2 Source: Dr. Kasthuri Ve

🌍 Występowanie
Pantoea stewartii ssp. stewartii to bakteria wywołująca bakteryjne więdnięcie kukurydzy, występująca w wielu regionach świata. Patogen został stwierdzony w Azji, obejmując Chiny, Filipiny, Indie, Malezję i Tajlandię. W Afryce notowano go w Beninie i Togo. Na kontynencie amerykańskim bakteria występuje w Ameryce Północnej (Kanada, Meksyk, Stany Zjednoczone), Ameryce Środkowej (Kostaryka, Portoryko, Trynidad i Tobago) oraz Ameryce Południowej (Argentyna, Boliwia, Gujana, Peru).
W Europie patogen został wykryty w kilku krajach, w tym w Słowenii, we Włoszech, w Rosji i na Ukrainie. Obecnie bakteria nie występuje w Polsce, chociaż w przeszłości została przechwycona na nasionach kukurydzy wyprodukowanych w naszym kraju, co świadczy o potencjalnym zagrożeniu.
🌱 Rośliny żywicielskie
Podstawowym żywicielem bakterii jest kukurydza (Zea mays), przy czym szczególną wrażliwością charakteryzuje się kukurydza cukrowa. Porażeniu ulegają również inne typy kukurydzy, w tym kukurydza koński ząb, kukurydza twarda, kukurydza mączysta oraz kukurydza pękająca.
Jako alternatywny żywiciel wskazywana jest trawa Setaria pallidefusca. Sporadycznie bakterię stwierdzano również na innych gatunkach roślin, takich jak chlebowiec różnolistny (Artocarpus heterophyllus), dracena Sandera (Dracaena sanderiana), Tripsiacum dactyloides, Zea maxicana oraz na różnych przedstawicielach rodziny wiechlinowatych (Poaceae).
⚠️ Objawy porażenia
Nasiona kukurydzy porażone przez bakterię nie wykazują zewnętrznych objawów infekcji. Pierwsze symptomy choroby mogą pojawić się już we wczesnym stadium rozwoju rośliny, w fazie siewki, gdy może nastąpić więdnięcie młodych roślin. W przypadku późniejszej infekcji rośliny osiągają większe rozmiary przed ujawnieniem się objawów.
Charakterystycznymi symptomami są zmiany w wyglądzie liści, które stają się jasnozielone do żółtych, z podłużnymi smugami i nieregularnymi lub pofałdowanymi brzegami. Wzdłuż unerwienia liścia pojawiają się początkowo krótkie, nieregularne, opalizująco-zielone do żółtych smugi, powstające w miejscach żerowania wektora bakterii – chrząszczy Chaetocnema pulicaria. Tkanka blaszki liściowej w obrębie tych smug stopniowo wysycha i brązowieje.
Na łuskach kolb mogą pojawiać się małe wodniste plamy, które w warunkach wysokiej wilgotności prowadzą do wycieku kropli śluzu bakteryjnego na wewnętrznej powierzchni łuski. Rośliny, które przeżyją infekcję, mogą wytworzyć zbielałe, martwe kwiatostany. W przypadku silnego porażenia w rdzeniu dolnej części łodygi, przy powierzchni gleby, powstają zagłębienia.
Więdnięcie liści jest szczególnie widoczne po okresie kwitnienia. Całe liście przyjmują barwę słomkową i zamierają, a osłabione chorobą rośliny wykazują zwiększoną podatność na grzybową zgniliznę łodygi.
📉 Szkodliwość
Bakteryjne więdnięcie kukurydzy jest chorobą o znacznym potencjale szkodliwości, wywołującą poważne obniżenie plonów. Straty w zbiorach kukurydzy mogą wynosić od kilkudziesięciu procent do całkowitej utraty plonu, w skrajnych przypadkach sięgając 100%. Choroba stanowi zatem istotne zagrożenie ekonomiczne dla producentów kukurydzy w regionach, gdzie patogen występuje.
🔄 Sposoby rozprzestrzeniania
W warunkach naturalnych bakteria rozprzestrzenia się głównie przy pomocy wektora – chrząszczy z gatunku Chaetocnema pulicaria. Prawdopodobnie w przenoszeniu patogena mogą uczestniczyć także skoczki. Transport bakterii na większe odległości następuje z materiałem siewnym – porażonymi nasionami kukurydzy, co stanowi główną drogę międzynarodowego rozprzestrzeniania się patogena.
🛡️ Zwalczanie
Podstawowym sposobem zapobiegania chorobie jest stosowanie zdrowego materiału siewnego, wolnego od patogena. Istotne znaczenie ma również kontrola wektorów – owadów przenoszących bakterię. W przypadku podejrzenia wystąpienia bakterii w uprawach kukurydzy konieczne jest zgłoszenie tego faktu do właściwej terytorialnie jednostki Państwowej Inspekcji Ochrony Roślin i Nasiennictwa.
⚖️ Status prawny
W Unii Europejskiej, w tym w Polsce, Pantoea stewartii ssp. stewartii (wcześniej klasyfikowana jako Erwinia stewartii ssp. stewartii) podlega obowiązkowi zwalczania jako agrofag kwarantannowy. Wymaga to szczególnego nadzoru fitosanitarnego nad importowanym materiałem siewnym kukurydzy oraz monitoringu krajowych upraw w celu wczesnego wykrycia ewentualnego pojawienia się choroby.
📚 Źródła
- Ulotka informacyjna PIORiN (PDF)
- EPPO Global Database